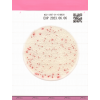
Easy Plate AC - Placi Testare Microbiologica Aeroba, Numarare Totala Bacterii
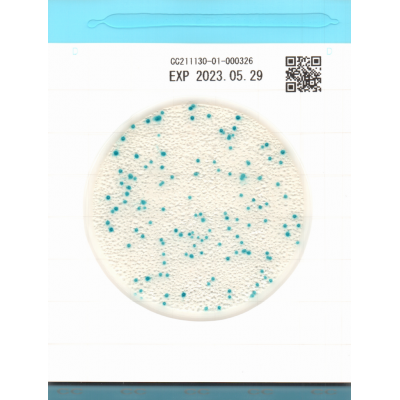
Easy Plate CC - Sistem Testare Microbiologica Coliforme, Placi Test Ready-to-Use

Easy Plate CC - Sistem Testare Microbiologica Coliforme, Placi Test Ready-to-Use
Transport Gratuit
Pentru comenzi peste 500 lei
Calitatea produselor garantata
Un nivel ridicat de calitate va determina o satisfacție mai deplină a clientului
Easy Plate CC reprezinta sistemul inovator de testare microbiologica destinat detectiei si numararii bacteriilor coliforme in produsele alimentare. Acest dispozitiv ready-to-use certificat AOAC-PTM ofera o alternativa moderna la metoda traditionala Violet Red Bile Agar, combinand precizie ridicata, operare simpla si eficienta maxima in laboratorul dvs.
Caracteristici Principale
Certificari si Standarde Internationale:
- Certificat AOAC PTM - recunoscut la nivel mondial
- Validat NordVal si MicroVal pentru precizie maxima
- Alternativa oficiala la Violet Red Bile Agar
Design Inovator si Functionalitate:
- Folie impermeabila cu mediu uscat preparat
- Capac transparent pentru monitorizare usoara
- Autodifuzant - proba se raspandeste automat pe supfata
- Nu necesita echipament specializat de laborator
- Gata de utilizare - fara preparare prealabila
- Protocol simplu in 3 pasi: extragere proba, pipetare, incubare
Metoda Easy Plate CC a primit certificarea SM de performanta a Institutului de Cercetare AOAC (pentru carne de porc crudă tocata, carne de porc cruda tocata, pui crud tocat, file de ton crud, file de somon crud, creveti crudi, banane proaspete decojite, ananas proaspat taiat si mere proaspat taiate).
Specificatii Tehnice
| Produs | Easy Plate® CC |
| Producator | Easy Plate |
| Microorganisme tinta | Escherichia coli, Bacterii coliforme |
| Aplicatie | Testare probe carne,peste, fructe |
| Timp de incubare | 28 ore |
| Temperatura de incubare | 35 grade |
| Depozitare | 2-8 °C |
| Certificari | AOAC-PTM NordVal MicroVal |
| Continut pachet | 100 placi |
Set de produse